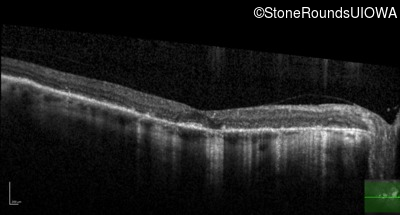
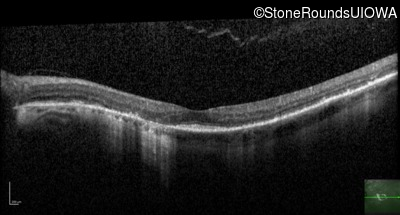
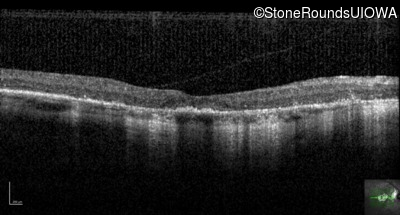
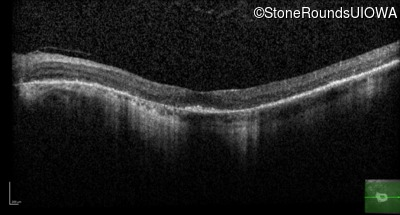
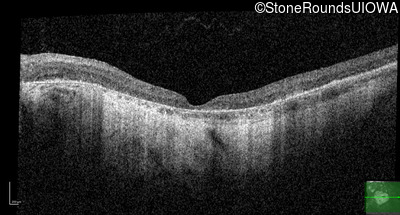

Case
SR1761
Student Mode
Pattern Dystrophy (IIC)
Male
Male
Hidden
SR1761
Student Mode
Pattern Dystrophy (IIC)
Male
Male
History
This 62 year old man first noted mild distortion in his vision in his 30's, but has always been correctable to 20/20. One year ago an optometrist told him there were pigment abnormalities in his macula.
| Age at visit: 62 years |
| Age at visit: 64 years |
Diagnosis & molecular findings
| Disease | Gene | Allele 1 variant(s) | Allele 2 variant(s) | Inheritance mode |
|---|---|---|---|---|
| Pattern Dystrophy | PRPH2 | Lys153Glu AAG>GAG | AD |